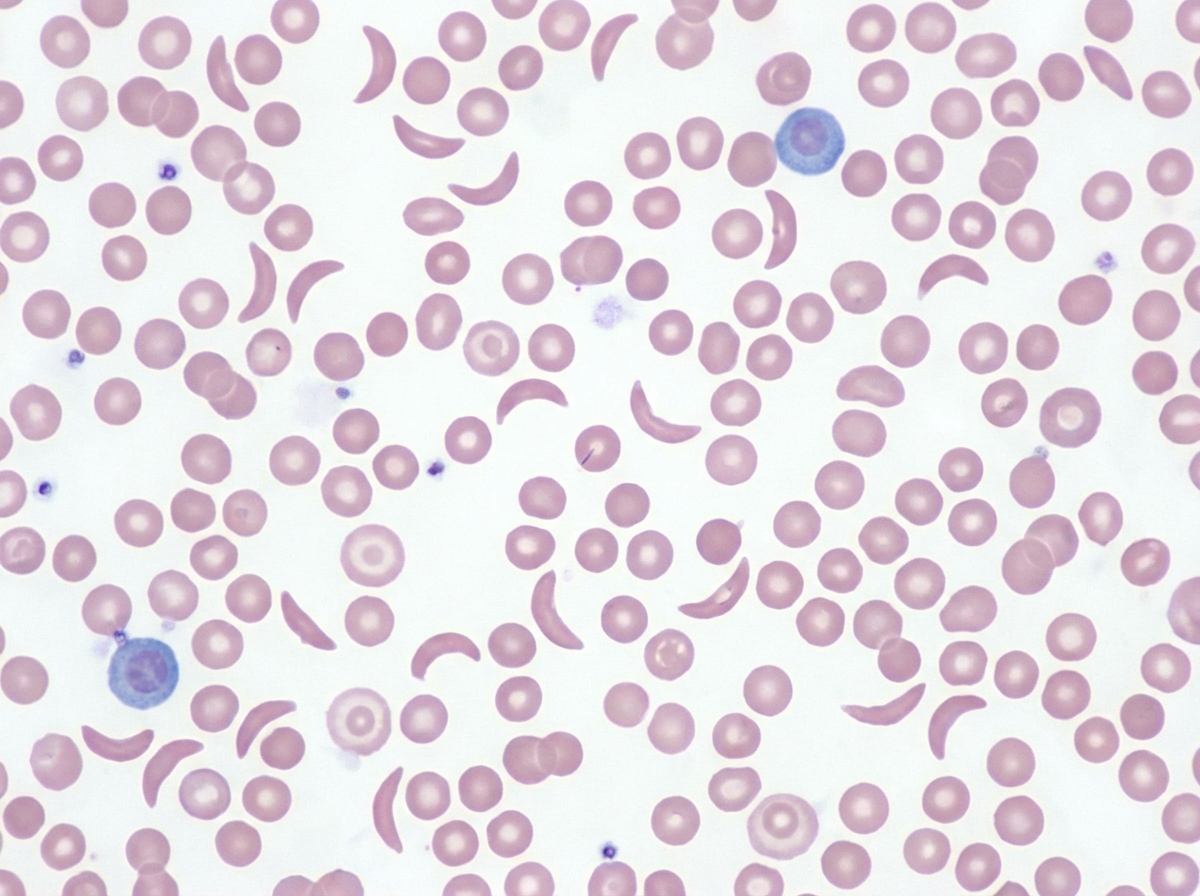
Image for question 701

This is the peripheral smear of which disease?
BCR-ABL1 gene fusion is seen in all of the following conditions except?
Which type of Hodgkin's disease is commonest in females and associated with an excellent prognosis?
Which coagulation test is typically prolonged in hemophilia?
Which subtype of Hodgkin lymphoma is associated with the maximum incidence of 'B' symptoms?
Bence Jones proteinuria may be seen in:
Which of the following is NOT a characteristic feature of multiple myeloma?
Splenic auto-infarction is typically seen in which of the following conditions?
Raised aPTT is seen in all of the following bleeding disorders except?
What is the highest level of LAP seen in?
Explanation: ***Sickle cell anemia*** - The peripheral smear shows characteristic **drepanocytes** (sickle-shaped red blood cells) which are pathognomonic for sickle cell anemia. - These **crescent-shaped cells** result from **hemoglobin S polymerization** under deoxygenated conditions, causing the distinctive morphology. *Thalassemia* - Shows **microcytic hypochromic** red blood cells with **target cells** and **tear drop cells**, not sickle-shaped cells. - **Hemoglobin electrophoresis** would reveal elevated **HbA2** and **HbF** levels, distinguishing it from sickle cell disease. *Iron deficiency anemia* - Characterized by **microcytic hypochromic** red blood cells that are small and pale with increased **central pallor**. - Shows **pencil cells** and **target cells** occasionally, but never the characteristic **sickle-shaped morphology**. *Sideroblastic anemia* - Demonstrates a **dimorphic blood picture** with both **microcytic** and **normocytic** red blood cells present. - **Ringed sideroblasts** are seen in bone marrow with **Prussian blue staining**, but peripheral smear lacks sickle cells.
Explanation: **Explanation:** The **BCR-ABL1** fusion gene, located on the **Philadelphia chromosome [t(9;22)(q34;q11)]**, encodes a constitutively active tyrosine kinase [1], [4]. This mutation is the hallmark of certain myeloid and lymphoid malignancies but is **not** associated with Chronic Lymphocytic Leukemia (CLL) [2]. * **Why Option D is correct:** **Chronic Lymphocytic Leukemia (CLL)** is a mature B-cell neoplasm. Its pathogenesis typically involves deletions (13q, 11q, 17p) or Trisomy 12, rather than the BCR-ABL1 translocation [2]. Therefore, it is the correct "except" choice. * **Why Option B is incorrect:** **Chronic Myeloid Leukemia (CML)** is defined by the presence of BCR-ABL1 (typically the p210 isoform) in 100% of cases [1], [4]. It is the diagnostic gold standard. * **Why Option C is incorrect:** **Acute Lymphoblastic Leukemia (ALL)** exhibits the Philadelphia chromosome in approximately 25-30% of adults and 3-5% of children (typically the p190 isoform) [4]. It signifies a poor prognosis. * **Why Option A is incorrect:** **Acute Myeloid Leukemia (AML)** can occasionally harbor the BCR-ABL1 mutation (rarely, <1% of cases). It is recognized as a formal provisional entity in the WHO classification (AML with BCR-ABL1). **High-Yield Clinical Pearls for NEET-PG:** 1. **Isoforms:** * **p210:** Classic CML [4]. * **p190:** Most common in Ph+ ALL (associated with a "lymphoid-only" hit). * **p230:** Associated with Chronic Neutrophilic Leukemia (CNL). 2. **Treatment:** The discovery of BCR-ABL1 led to the development of **Imatinib**, a tyrosine kinase inhibitor (TKI), which revolutionized the management of CML [3], [4]. 3. **CLL Hallmark:** Look for "Smudge cells" and CD5/CD23 positivity on flow cytometry. **References:** [1] Kumar V, Abbas AK, et al.. Robbins and Cotran Pathologic Basis of Disease. 9th ed. Diseases of White Blood Cells, Lymph Nodes, Spleen, and Thymus, p. 624. [2] Cross SS. Underwood's Pathology: A Clinical Approach. 6th ed. Common Clinical Problems From Blood And Bone Marrow Disease, pp. 612-613. [3] Cross SS. Underwood's Pathology: A Clinical Approach. 6th ed. Common Clinical Problems From Blood And Bone Marrow Disease, pp. 611-612. [4] Kumar V, Abbas AK, et al.. Robbins and Cotran Pathologic Basis of Disease. 9th ed. Diseases of White Blood Cells, Lymph Nodes, Spleen, and Thymus, pp. 624-625.
Explanation: **Explanation:** **Nodular Sclerosis (NSHL)** is the most common subtype of Classical Hodgkin Lymphoma (CHL), accounting for approximately 60–70% of cases. It is unique among Hodgkin subtypes because it shows a **female predominance** and typically affects adolescents or young adults [1]. Pathologically, it is characterized by broad bands of collagen fibrosis encircling lymphoid nodules and the presence of **Lacunar cells** (a variant of Reed-Sternberg cells) [2]. It frequently involves the mediastinum [1] and carries an **excellent prognosis** [2]. **Analysis of Incorrect Options:** * **Lymphocyte Predominant (NLPHL):** While this has the *best* overall prognosis, it is more common in **males** (30–50 years) and is characterized by "Popcorn cells" (L&H cells). It is distinct from Classical HL as it is CD20+ and CD15/30 negative. * **Mixed Cellularity:** This is the second most common type. It is more common in older males, strongly associated with **EBV (70%)** [2], and presents with frequent constitutional (B) symptoms [2]. * **Lymphocyte Depleted:** This is the rarest and most aggressive form [3] with the **worst prognosis**. It is typically seen in elderly or HIV-positive patients and is characterized by abundant RS cells and few lymphocytes [3]. **High-Yield Pearls for NEET-PG:** * **Most common overall:** Nodular Sclerosis. * **Best prognosis:** Lymphocyte Predominant (NLPHL). * **Worst prognosis:** Lymphocyte Depleted [3]. * **Strongest EBV association:** Mixed Cellularity [2] (followed by Lymphocyte Depleted). * **RS Cell Markers (Classical HL):** CD15+, CD30+, CD45–. * **Lacunar cells** are an artifact of formalin fixation seen specifically in Nodular Sclerosis. **References:** [1] Cross SS. Underwood's Pathology: A Clinical Approach. 6th ed. Common Clinical Problems From Diseases Of The Urinary And Male Genital Tracts, pp. 558-559. [2] Kumar V, Abbas AK, et al.. Robbins and Cotran Pathologic Basis of Disease. 9th ed. Diseases of White Blood Cells, Lymph Nodes, Spleen, and Thymus, pp. 616-618. [3] Cross SS. Underwood's Pathology: A Clinical Approach. 6th ed. Common Clinical Problems From Diseases Of The Urinary And Male Genital Tracts, pp. 559-560.
Explanation: **Explanation:** Hemophilia (A and B) is a disorder of the **intrinsic pathway** of the coagulation cascade. Hemophilia A is caused by a deficiency of Factor VIII, while Hemophilia B (Christmas disease) is caused by a deficiency of Factor IX [1]. 1. **Why APTT is correct:** The **Activated Partial Thromboplastin Time (APTT)** measures the integrity of the intrinsic and common pathways (Factors XII, XI, IX, VIII, X, V, II, and I). Since Hemophilia involves a deficiency in Factor VIII or IX, the APTT will be characteristically **prolonged** [1]. 2. **Why other options are incorrect:** * **Prothrombin Time (PT):** This measures the **extrinsic pathway** (Factor VII) and the common pathway. Since Factor VII levels are normal in hemophilia, the PT remains normal [1]. * **Clotting Time (CT):** While CT can be prolonged in severe hemophilia, it is a crude, insensitive, and non-specific test that is no longer used for diagnosis in modern clinical practice. * **Fibrin Degradation Products (FDP):** These are markers of fibrinolysis (e.g., seen in DIC). They are not affected by isolated factor deficiencies like hemophilia. **High-Yield Clinical Pearls for NEET-PG:** * **Mixing Study:** If APTT is prolonged, a mixing study (patient plasma + normal plasma) is performed. If the APTT **corrects**, it indicates a factor deficiency (like Hemophilia). If it does **not** correct, it suggests the presence of an inhibitor (e.g., Lupus anticoagulant). * **Bleeding Time (BT):** BT measures platelet function. In Hemophilia, BT is **normal** because primary hemostasis (platelet plug formation) is unaffected. * **Inheritance:** Both Hemophilia A and B are **X-linked recessive** disorders [1]. * **Common Presentation:** Hemarthrosis (bleeding into joints) and muscle hematomas. **References:** [1] Cross SS. Underwood's Pathology: A Clinical Approach. 6th ed. Common Clinical Problems From Blood And Bone Marrow Disease, pp. 622-623.
Explanation: **Explanation:** In Hodgkin Lymphoma (HL), **'B' symptoms** (fever, night sweats, and weight loss) are primarily driven by the release of cytokines (such as IL-1, IL-6, and TNF-alpha) from the reactive inflammatory background surrounding the Reed-Sternberg (RS) cells. **Why Mixed Cellularity (MC) is the correct answer:** The Mixed Cellularity subtype is characterized by a high number of RS cells and a diverse inflammatory infiltrate (lymphocytes, plasma cells, eosinophils, and macrophages). Because it has a higher burden of RS cells compared to the lymphocyte-rich types and is frequently associated with **EBV infection (70% of cases)**, there is a significant systemic cytokine release [1]. Consequently, it has the **highest incidence of B-symptoms (approx. 50-70% of cases)** and often presents at an advanced stage (III or IV) [1]. **Analysis of Incorrect Options:** * **Nodular Sclerosis (NS):** This is the most common subtype overall. While it can present with B-symptoms, the incidence is lower than in the MC subtype. It typically presents as a mediastinal mass in young females [1]. * **Lymphocyte Predominant (LP):** This subtype (specifically Nodular Lymphocyte Predominant HL) has the **best prognosis** and the **lowest incidence** of B-symptoms [2]. It usually presents as localized peripheral lymphadenopathy [2]. * **Lymphocyte Rich (LR):** This is a rare subtype with a very good prognosis and infrequent B-symptoms. **High-Yield Pearls for NEET-PG:** * **Best Prognosis:** Lymphocyte Predominant HL [2]. * **Worst Prognosis:** Lymphocyte Depleted HL (also has high B-symptoms, but MC is the classic answer for "maximum incidence" among common types). * **Most Common Subtype:** Nodular Sclerosis [1]. * **EBV Association:** Highest in Lymphocyte Depleted (>90%) and Mixed Cellularity (70%) [1]. * **RS Cell Variant:** "Lacunar cells" are characteristic of Nodular Sclerosis; "Popcorn cells" (L&H cells) are seen in Lymphocyte Predominant HL [2]. **References:** [1] Kumar V, Abbas AK, et al.. Robbins and Cotran Pathologic Basis of Disease. 9th ed. Diseases of White Blood Cells, Lymph Nodes, Spleen, and Thymus, pp. 616-618. [2] Kumar V, Abbas AK, et al.. Robbins and Cotran Pathologic Basis of Disease. 9th ed. Diseases of White Blood Cells, Lymph Nodes, Spleen, and Thymus, p. 618.
Explanation: **Explanation:** **Bence Jones proteins (BJP)** are free monoclonal immunoglobulin light chains (kappa or lambda) that are filtered by the glomerulus and excreted in the urine [1]. Their presence is a hallmark of plasma cell dyscrasias where there is an imbalance between heavy and light chain production [2]. **Why Mu Heavy Chain Disease is the Correct Answer:** Heavy Chain Diseases (HCDs) are rare B-cell proliferative disorders characterized by the production of truncated heavy chains without associated light chains. However, **Mu heavy chain disease (μ-HCD)** is a unique exception. Unlike Alpha or Gamma HCD, approximately **two-thirds of patients with Mu-HCD also produce monoclonal light chains**, which are excreted in the urine as **Bence Jones proteins**. This makes it the only HCD where BJP is a common finding. **Analysis of Incorrect Options:** * **Alpha (α) Heavy Chain Disease:** The most common HCD (associated with IPSID). It characteristically involves the gastrointestinal tract. Light chain production is almost **never** seen; hence, BJP is absent. * **Gamma (γ) Heavy Chain Disease (Franklin’s Disease):** Presents like a lymphoma. While it involves heavy chains, it is typically characterized by the **absence** of light chain secretion (no BJP). * **Epsilon (ε) Heavy Chain Disease:** An extremely rare condition. Similar to other HCDs (except Mu), it does not typically manifest with free light chain excretion. **NEET-PG High-Yield Pearls:** * **Bence Jones Protein Heat Test:** They precipitate at 40–60°C and **redissolve on boiling** (100°C). * **Detection:** BJP are **not** detected by standard urine dipsticks (which detect albumin); they require **Sulphosalicylic acid (SSA) test** or Urine Protein Electrophoresis (UPEP). * **Mu-HCD Clinical Clue:** Often associated with **Chronic Lymphocytic Leukemia (CLL)** and characterized by "vacuolated plasma cells" in the bone marrow. [3] **References:** [1] Cross SS. Underwood's Pathology: A Clinical Approach. 6th ed. Common Clinical Problems From Blood And Bone Marrow Disease, pp. 616-617. [2] Kumar V, Abbas AK, et al.. Robbins and Cotran Pathologic Basis of Disease. 9th ed. Diseases of White Blood Cells, Lymph Nodes, Spleen, and Thymus, pp. 608-609. [3] Kumar V, Abbas AK, et al.. Robbins and Cotran Pathologic Basis of Disease. 9th ed. Diseases of White Blood Cells, Lymph Nodes, Spleen, and Thymus, pp. 607-608.
Explanation: **Explanation:** In Multiple Myeloma (MM), the primary pathology involves the neoplastic proliferation of plasma cells, which secrete osteoclast-activating factors (like IL-6 and RANKL) [1]. This leads to **purely lytic bone lesions** without any osteoblastic (bone-forming) activity. **Why Option C is the correct answer (The "NOT" feature):** Serum Alkaline Phosphatase (ALP) is a marker of osteoblastic activity. Since the bone destruction in MM is purely lytic and lacks a compensatory osteoblastic response, **Serum ALP levels typically remain normal**. An elevated ALP in a suspected MM patient should prompt a search for an alternative diagnosis or a pathological fracture. **Analysis of other options:** * **A. Hypercalcemia:** This is a classic feature (part of the **CRAB** criteria). Extensive bone resorption by osteoclasts releases calcium into the bloodstream [1]. * **B. Hyperuricemia:** High cell turnover and the breakdown of nucleic acids from neoplastic plasma cells lead to increased uric acid levels. * **D. Monoclonal M band:** This is a hallmark finding on Serum Protein Electrophoresis (SPEP), representing the "M-spike" due to the production of monoclonal immunoglobulins (usually IgG or IgA) [2]. **NEET-PG High-Yield Pearls:** * **CRAB Criteria:** **C**alcium (High), **R**enal insufficiency, **A**nemia, **B**one lesions [1]. * **Radiology:** "Punched-out" lytic lesions on a skeletal survey [1], [3]; **Technetium-99m bone scans are often negative** because they detect osteoblastic activity. * **Peripheral Smear:** **Rouleaux formation** due to increased globulins [4]. * **Urine:** Bence-Jones proteins (free light chains) which precipitate at 40-60°C and redissolve at 100°C [4]. **References:** [1] Kumar V, Abbas AK, et al.. Robbins and Cotran Pathologic Basis of Disease. 9th ed. Diseases of White Blood Cells, Lymph Nodes, Spleen, and Thymus, p. 608. [2] Cross SS. Underwood's Pathology: A Clinical Approach. 6th ed. Common Clinical Problems From Blood And Bone Marrow Disease, pp. 616-617. [3] Cross SS. Underwood's Pathology: A Clinical Approach. 6th ed. Common Clinical Problems From Blood And Bone Marrow Disease, pp. 617-618. [4] Kumar V, Abbas AK, et al.. Robbins and Cotran Pathologic Basis of Disease. 9th ed. Diseases of White Blood Cells, Lymph Nodes, Spleen, and Thymus, pp. 607-608.
Explanation: **Explanation:** **1. Why Sickle Cell Disease (SCD) is correct:** Splenic auto-infarction is a hallmark of **Sickle Cell Anemia (HbSS)**. The underlying mechanism involves the polymerization of deoxygenated Hemoglobin S, causing RBCs to "sickle" [2]. These rigid cells become trapped in the narrow splenic sinusoids, leading to microvascular occlusion (vaso-occlusion). Repeated episodes of ischemia and infarction cause the spleen to progressively shrink, fibrose, and calcify [3]. By adulthood, the spleen is often reduced to a small, non-functional fibrous remnant—a process termed **autosplenectomy** [4]. **2. Why the other options are incorrect:** * **Splenic Amyloidosis:** Typically results in **splenomegaly**. Depending on the pattern of deposition, it presents as "Sago spleen" (white pulp involvement) or "Lardaceous spleen" (red pulp involvement). * **Thalassemia:** Characterized by significant **splenomegaly** due to extramedullary hematopoiesis and increased destruction of abnormal RBCs (work hypertrophy). * **Gaucher Disease:** This lysosomal storage disorder causes **massive splenomegaly** due to the accumulation of glucosylceramide in splenic macrophages (Gaucher cells). **3. Clinical Pearls for NEET-PG:** * **Howell-Jolly Bodies:** Their presence on a peripheral smear indicates splenic dysfunction (functional asplenia) following auto-infarction [4]. * **Infection Risk:** Patients with auto-infarction are highly susceptible to **encapsulated organisms** (e.g., *Streptococcus pneumoniae*, *Haemophilus influenzae*, *Neisseria meningitidis*) due to loss of splenic filtering [1]. * **Radiology:** On X-ray or CT, an auto-infarcted spleen appears as a small, shrunken, and **hyperdense/calcified** mass in the left upper quadrant. * **Sequestration Crisis:** Note that in children with SCD, the spleen is initially enlarged before auto-infarction occurs; sudden pooling of blood here can lead to life-threatening hypovolemia [4]. **References:** [1] Kumar V, Abbas AK, et al.. Robbins and Cotran Pathologic Basis of Disease. 9th ed. Diseases of White Blood Cells, Lymph Nodes, Spleen, and Thymus, pp. 631-632. [2] Cross SS. Underwood's Pathology: A Clinical Approach. 6th ed. Common Clinical Problems From Blood And Bone Marrow Disease, pp. 598-599. [3] Kumar V, Abbas AK, et al.. Robbins and Cotran Pathologic Basis of Disease. 9th ed. Red Blood Cell and Bleeding Disorders, pp. 645-646. [4] Kumar V, Abbas AK, et al.. Robbins and Cotran Pathologic Basis of Disease. 9th ed. Red Blood Cell and Bleeding Disorders, pp. 644-645.
Explanation: **Explanation:** The **activated Partial Thromboplastin Time (aPTT)** measures the integrity of the **intrinsic** and **common pathways** of the coagulation cascade. It becomes prolonged when there is a deficiency or inhibition of factors XII, XI, IX, VIII, X, V, II (prothrombin), or I (fibrinogen). **Why Henoch-Schönlein Purpura (HSP) is the correct answer:** HSP is a **small-vessel vasculitis** (IgA-mediated). The bleeding manifestations in HSP are due to **vascular inflammation and fragility**, not a defect in the coagulation cascade or platelets. Therefore, in HSP, the aPTT, PT, and platelet counts are typically **normal**. **Why the other options are incorrect:** * **Hemophilia A:** Caused by a deficiency of **Factor VIII** [1], [2], a key component of the intrinsic pathway. This leads to a prolonged aPTT. * **Hemophilia B:** Caused by a deficiency of **Factor IX** [2], also part of the intrinsic pathway, resulting in a prolonged aPTT. * **Von-Willebrand Disease (vWD):** vWF acts as a carrier protein for Factor VIII, protecting it from degradation. In vWD, low levels of vWF lead to a secondary decrease in **Factor VIII** levels, which frequently results in a raised aPTT [2]. **NEET-PG High-Yield Pearls:** 1. **HSP Tetrad:** Palpable purpura (without thrombocytopenia), arthralgia, abdominal pain, and renal involvement (IgA nephropathy). 2. **Mixing Study:** If aPTT is prolonged, a mixing study is done. If it corrects, it indicates a **factor deficiency**; if it doesn't, it indicates a **factor inhibitor** (e.g., Lupus anticoagulant). 3. **Isolated raised aPTT:** Think Hemophilia A, B, or Factor XII deficiency (Hageman factor—causes high aPTT but no clinical bleeding). 4. **Vitamin K deficiency/Warfarin:** Primarily affects PT first (due to short half-life of Factor VII) before affecting aPTT [3]. **References:** [1] Kumar V, Abbas AK, et al.. Robbins and Cotran Pathologic Basis of Disease. 9th ed. Red Blood Cell and Bleeding Disorders, pp. 670-671. [2] Cross SS. Underwood's Pathology: A Clinical Approach. 6th ed. Common Clinical Problems From Blood And Bone Marrow Disease, pp. 622-623. [3] Cross SS. Underwood's Pathology: A Clinical Approach. 6th ed. Common Clinical Problems From Blood And Bone Marrow Disease, pp. 624-625.
Explanation: The **Leukocyte Alkaline Phosphatase (LAP) score** (also known as the Neutrophil Alkaline Phosphatase/NAP score) measures the activity of the enzyme alkaline phosphatase within the secondary granules of mature neutrophils. **1. Why Polycythemia Vera (PV) is correct:** In Myeloproliferative Neoplasms (MPNs) like **Polycythemia Vera** and Essential Thrombocythemia, there is an effective overproduction of mature myeloid cells [1]. These cells are functionally normal and contain high levels of LAP enzyme. PV typically shows the **highest levels of LAP**, often exceeding 100–200 (Normal range: 40–120). Other conditions with high LAP include Leukemoid reactions and pregnancy. **2. Analysis of Incorrect Options:** * **Chronic Myeloid Leukemia (CML):** This is the classic "high-yield" contrast. In CML, despite a high white cell count, the LAP score is **characteristically low or zero** because the neoplastic neutrophils are biochemically defective [1]. (Note: LAP may rise during a blast crisis or concurrent infection). * **Acute Myeloid Leukemia (AML):** LAP scores are generally low or irrelevant in AML because the predominant cells are immature blasts, which do not contain the secondary granules where the LAP enzyme resides. * **Paroxysmal Nocturnal Hemoglobinuria (PNH):** This is a stem cell disorder where the deficiency of GPI-anchored proteins leads to a **low LAP score**, as the LAP enzyme itself is GPI-linked to the neutrophil membrane. **High-Yield Clinical Pearls for NEET-PG:** * **LAP Score Increase:** Leukemoid Reaction, Polycythemia Vera, Pregnancy, Stress/Infection, Cushing’s Syndrome. * **LAP Score Decrease:** CML, PNH, Myelodysplastic Syndrome (MDS), Infectious Mononucleosis, Hypophosphatasia. * **Mnemonic:** "CML and PNH go Low; PV and Leukemoid go High." **References:** [1] Kumar V, Abbas AK, et al.. Robbins and Cotran Pathologic Basis of Disease. 9th ed. Diseases of White Blood Cells, Lymph Nodes, Spleen, and Thymus, pp. 625-627.
Anemias: Classification and Approach
Practice Questions
Hemolytic Anemias
Practice Questions
Myeloproliferative Neoplasms
Practice Questions
Myelodysplastic Syndromes
Practice Questions
Acute Leukemias
Practice Questions
Chronic Leukemias
Practice Questions
Lymphomas and Lymphoid Neoplasms
Practice Questions
Plasma Cell Disorders
Practice Questions
Bleeding Disorders
Practice Questions
Thrombotic Disorders
Practice Questions
Get full access to all questions, explanations, and performance tracking.
Start For Free